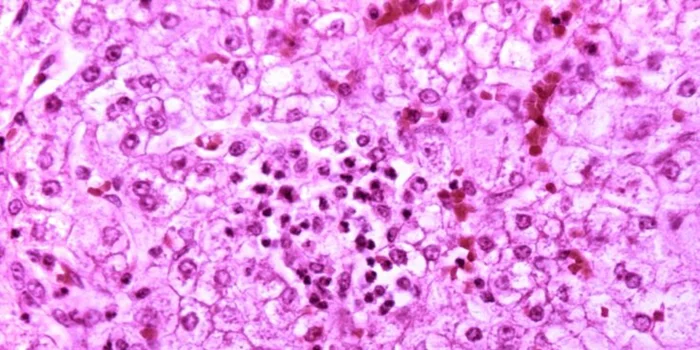

Аспирин: 5 малоизвестных фактов о популярном лекарстве
Как одна из самых известных таблеток связана с корой ивы и кто действительно её создал?

1. Лекарство, покорившее мир

Старинный аспирин в порошковой форме. Автор фото: Dan Smedley / Unsplash
Аспирин стал символом универсального средства для лечения боли и воспалений. Его используют при головных, зубных и суставных болях, а также для снижения температуры и лечения таких заболеваний, как лихорадка и ревматизм.
Исследования подтвердили: небольшие дозы препарата снижают риск сердечных приступов и инсультов, а также, возможно, предотвращают развитие рака прямой кишки, хотя механизм действия до конца не изучен.
Каждый год производится 40 тысяч тонн аспирина. В одних США 50 миллионов человек принимают от 10 до 20 миллиардов таблеток ежегодно, делая его одним из самых популярных медикаментов в истории.
2. У этого лекарства долгая история

Кора ивы. Автор фото: Alfred Kenneally / Unsplash
Всемирно известный аспирин базируется на ацетилсалициловой кислоте — веществе, известном с древности. Ещё шумеры и египтяне использовали отвары из коры ивы, богатой салицилатами, для лечения. Упоминания об этом есть в папирусе Эберса (1550 г. до н. э.) и трудах Гиппократа (400 г. до н. э.).
Однако салициловая кислота раздражала желудок, вызывая боль и тошноту, что ограничивало её применение.
3. История создания и спорная слава

Первая упаковка аспирина Bayer. Источник: Wikimedia Commons
Долгие годы считалось, что синтез ацетилсалициловой кислоты в 1897 году принадлежит Феликсу Хоффману, который хотел помочь своему отцу с ревматизмом. Однако исследования показали, что ключевую роль сыграл его руководитель Артур Эйхенгрюн.
Компания Bayer умолчала о его заслугах из-за антисемитской политики в нацистской Германии. Эйхенгрюн раскрыл свою роль в 1949 году, когда уже пережил ужасы концентрационного лагеря.
4. Имя от природы

Источник: Wikimedia Commons
Название «аспирин» появилось благодаря таволге (Spiraea ulmaria), из которой извлекали салициловую кислоту. Латинское spir в названии подчёркивает этот источник, а приставка а — реакцию ацетилирования.
5. Опасности аспирина
Синдром Рея. Источник: Wikimedia Commons
Несмотря на доступность, аспирин может быть опасным. Его побочные эффекты включают желудочные кровотечения, повреждение слуха и редкий синдром Рея у детей, когда препарат используют при вирусных заболеваниях.
Аспирин противопоказан пациентам младше 16 лет и требует консультации врача.